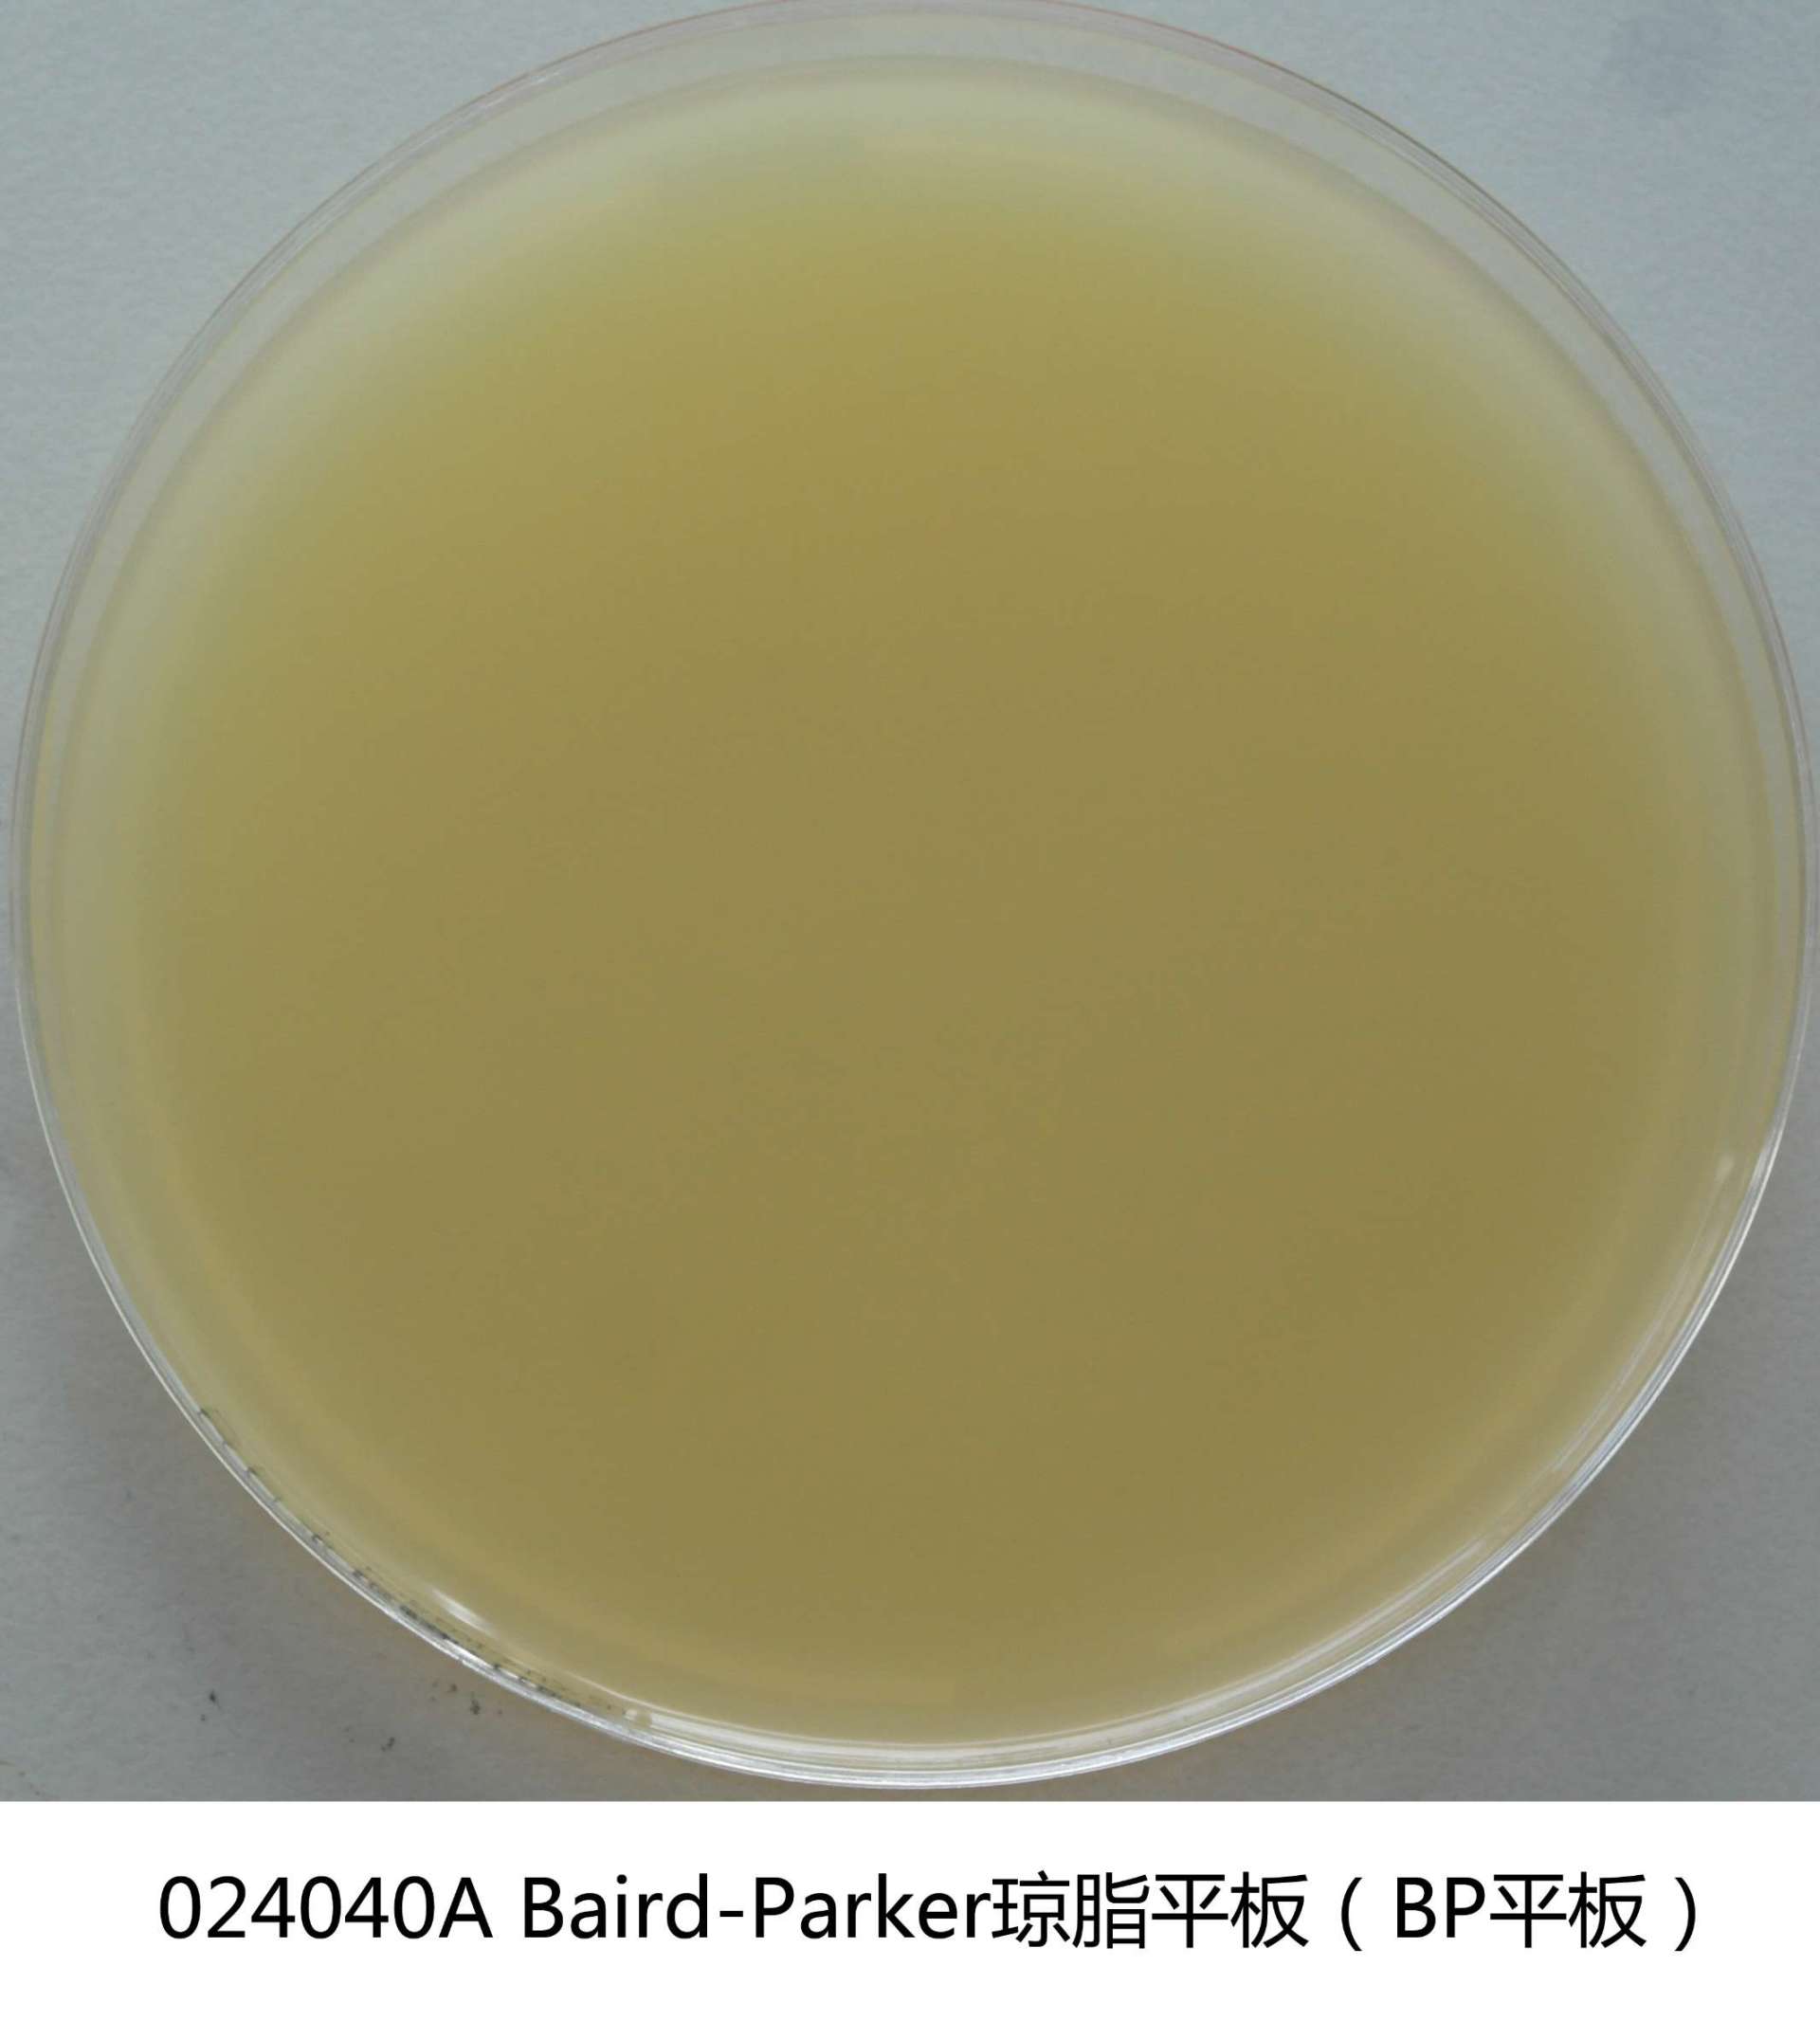
产品细节图片1

相关产品推荐更多 >
万千商家帮你免费找货
0 人在求购买到急需产品
- 详细信息
- 询价记录
- 文献和实验
- 技术资料
- 库存:
99999
- 英文名:
Baird-Parker Agar Plate
- CAS号:
ISO9001
- 保质期:
有效期见于产品标签
- 供应商:
环凯微生物
- 保存条件:
2-25℃贮存于避光、干燥处
- 规格:
90mm×20个/盒
产品名称:Baird-Parker琼脂平板
英文名称:Baird-Parker Agar Plate
产品编号与包装规格:
| 产品编号 | 产品类型 | 包装规格 |
| 024040A | 即用型成品 | 90mm×20个/盒 |
产品用途:用于凝固酶阳性葡萄球菌的选择性分离培养和计数。
检验原理:胰蛋白胨、牛肉膏粉和酵母膏粉提供碳氮源、维生素和生长因子;丙同酸钠和甘氨酸刺激葡萄球菌的生长;氯化锂和亚碲酸钾抑制非葡萄球菌的微生物;含有卵磷脂酶的葡萄球菌降解卵黄使菌落产生透明圈,而脂酶作用则产生不透明的沉淀环;凝固酶阳性的葡萄球菌还能还原亚碲酸钾而产生黑色菌落;琼脂是培养基的凝固剂。
配方成分:
| 配方(每升) | 含量 |
| 胰蛋白胨 | 10.0g |
| 牛肉膏粉 | 5.0g |
| 酵母膏粉 | 1.0g |
| 丙t酸钠 | 10.0g |
| 甘氨酸 | 12.0g |
| 氯化锂(LiCl·6H2O) | 5.0g |
| 琼脂 | 15.0g |
| 亚碲酸钾 | 0.1g |
| 卵黄 | 13.1g |
| 纯化水 | 930mL |
| 最终pH | |
使用方法:于洁净环境下拆开包装即可使用。
质量控制:下列质控菌株接种待测试培养基35~37℃,24h结果如下:
| 指标 | 质控菌株及编号 | 标准值 | 特征性反应 |
| 生长率 | 金黄色葡萄球菌ATCC25923 | PR=0.5~2.0 | 黑色凸起菌落,周围为一浑浊带,在其外层有一透明圈 |
| 金黄色葡萄球菌ATCC6538 | |||
| 特异性 | 表皮葡萄球菌CMCC(B)26069 | - | 黑色菌落,无浑浊带和透明圈 |
| 选择性 | 大肠埃希氏菌ATCC25922 | G≤1 | - |
| 大肠埃希氏菌ATCC8739 | G≤1 | - |
储存条件与保质期:贮存于2-25℃避光、干燥处;有效期见产品标签。
注意事项:质检报告可以登录环凯微生物培养基网站, 打开“质检报告”页面,输入产品批号下载。
废物处理:检测之后带菌物品置于121℃下高压灭菌30分钟后处理。
执行标准:Q/HKSJ 03 广东环凯微生物科技有限公司企业标准 普通微生物培养基
参考文献:GB 4789.10-2016 食品安全国家标准 食品微生物学检验 金黄色葡萄球菌检验




风险提示:丁香通仅作为第三方平台,为商家信息发布提供平台空间。用户咨询产品时请注意保护个人信息及财产安全,合理判断,谨慎选购商品,商家和用户对交易行为负责。对于医疗器械类产品,请先查证核实企业经营资质和医疗器械产品注册证情况。
- 作者
- 内容
- 询问日期
 文献和实验
文献和实验货物积压,也影响货物的及时出运,并使货主的仓储成本提高,造成较大的经济损失。 多年来很多食品微生物实验室都在探索和寻找一些准确性高,并快速的检测方法,最近我们分别从美国3M公司和法国生物梅里埃公司获得两种快速检测致病性金黄色葡萄球菌的培养基,其名称为: ① Petrifilm RSA. Count Plate(由美国3M公司研制生产),是一种薄膜型快速检测金黄色葡萄球菌的计数平板。 ② Baird-parker + RPF Agar.(由法国生物
随着现代医学及相关科学技术的发展,各学科相互交叉和渗透,医学微生物学检验技术已深入到细胞、分子和基因水平,许多新技术、新方法已在临床微生物实验室得到广泛应用。医学微生物学实验室的基本任务之一是利用微生物学检验技术,准确、快速检验和鉴定临床标本中的微生物,并对引起感染的微生物进行耐药性监测,为临床对感染性疾病诊断、治疗、流行病学调查及研究等提供科学依据。 第一节 微生物形态学检查 细菌形态学检查是细菌检验的重要方法之一,它是细菌分类和鉴定的基础,可根据其形态、结构
、操作最熟练的技术员进行认真地专门测定,选用最佳的试剂盒,检测之前,将恒箱、加样器等认真校正、调校正、调试,使用新的加样吸头等,即在最佳、最理想的条件下进行检测。除质控血清外同时测定阴性对照品和阳性对照品。并作双份测定,得出2个吸光值(A值),求出X。连续作20次,求出20个X,即X1……X20。从这20个数据中,求出OCV的X和SD。5.3.2常规条件下已知值质控血清变异(routine conditions variance-known value,简称RCVK)的测定。做常规检验的技术
 技术资料
技术资料暂无技术资料 索取技术资料










